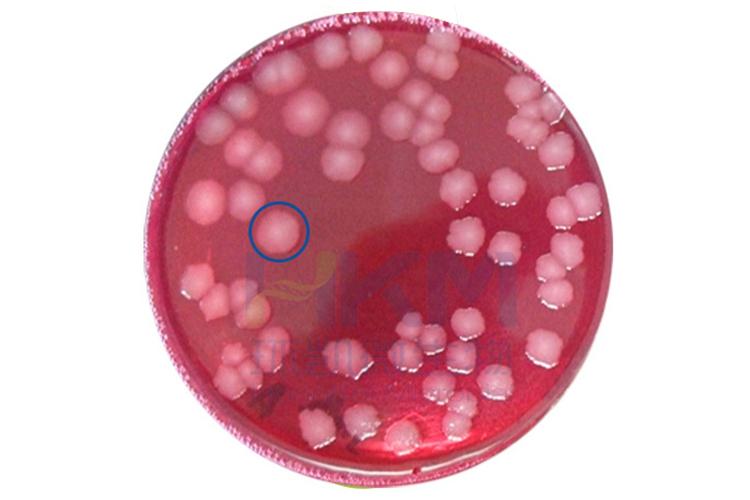

-

GB4789.6-2016 致泻大肠埃希氏菌检验及注意事项
致泻大肠埃希氏菌:一类能引起人体以腹泻症状为主的大肠埃希氏菌,可经过污染食物引起人类发病。
2021-11-26 -

更新 | GB4789.8-2016 小肠结肠炎耶尔森氏菌检验及其注意事项
GB4789.8-2016 小肠结肠炎耶尔森氏菌检验及其注意事项
2024-05-21 -

【新!】食品微生物检验GB4789.2-2022菌落总数测定及注意事项
菌落总数测定及注意事项详解GB4789.2-2022菌落总数测定变更情况、质量控制和疑难解析、菌落总数测试片法、所需培养基试剂等内容。
2020-08-28 -

更新 | GB 4789.13-2012 食品微生物学检验 产气荚膜梭菌检验
2024-07-03 -

食品微生物检验GB4789.3-2016大肠菌群计数及注意事项
大肠菌群计数及注意事项详解 GB4789.3-2016大肠菌群MPN法、GB4789.3-2016大肠菌群计数平板法、质量控制、大肠菌群测试片法、所需培养基试剂和质控菌株等内容。
2020-08-28 -
食品微生物检验GB4789.5-2012 志贺氏菌检验及注意事项
食品微生物检验GB4789.5-2012 志贺氏菌检验及注意事项详解志贺氏菌的生物学特性,志贺氏菌的检验、志贺氏菌检验所用培养基原理解析、志贺氏菌的生化鉴定等。
2020-11-18 -

GB4789.12-2016 肉毒梭菌及肉毒素检验
GB4789.12-2016 肉毒梭菌及肉毒素检验
2024-06-28 -

更新 | GB4789.10-2016金黄色葡萄球菌检验及其注意事项
GB4789.10-2016金黄色葡萄球菌检验及其注意事项
2024-06-12 -

EasyBox余氯快检技术的应用
环凯EasyBox余氯快检技术在自来水余氯检测的应用。
2021-02-23 -

唐菖蒲伯克霍尔德氏菌(椰毒假单胞菌酵米面亚种)检验解决方案
唐菖蒲伯克霍尔德氏菌(椰毒假单胞菌酵米面亚种)检验解决方案,传统检测方案及恒温荧光扩增试剂盒快速检测方案。
2020-09-10






